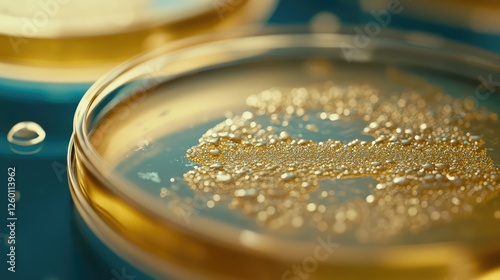

Download sample
File Details
Published: 2025-02-12 11:11:02.938494 Category: Science Type: Illustration Model release: NoShare
A close-up of a petri dish with bacteria cultures, surrounded by blank space for copy or branding placement.
Contributor: pinporn manosri
ID : 1260113962
